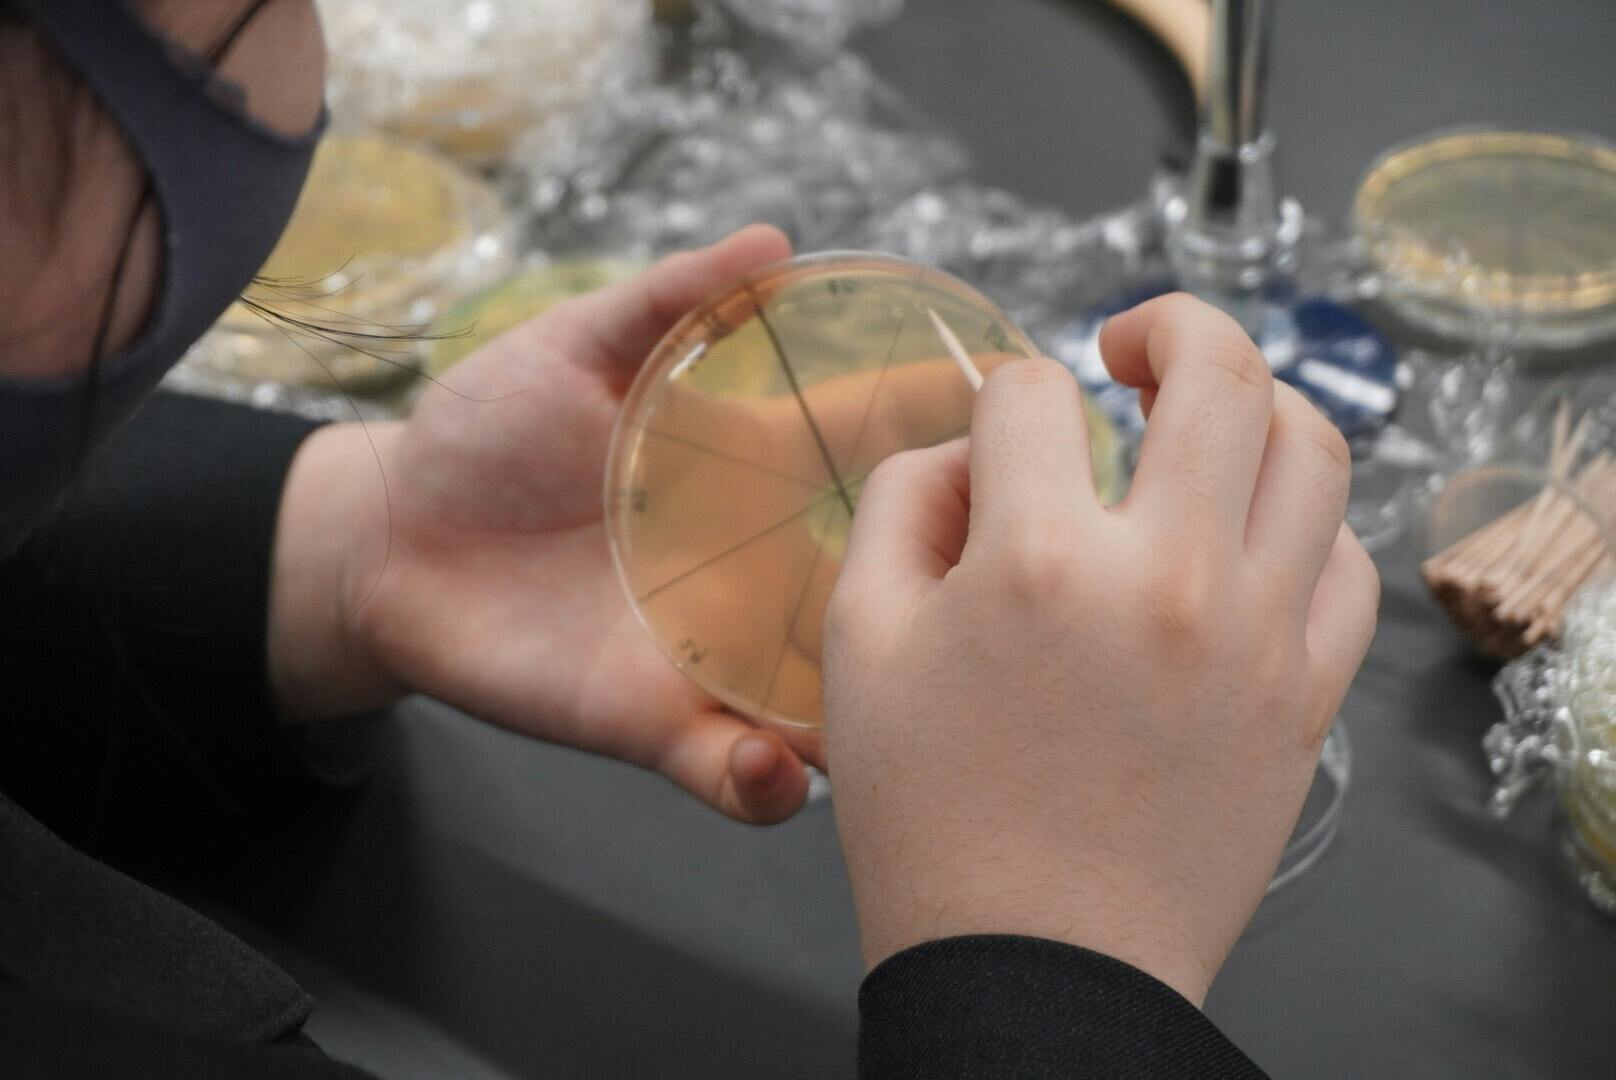

はじめに

私達iGEM Grand Tokyo は日本代表の高校生チームとして合成生物学の国際大会iGEM 2024に出場します。同世代の中でも「尖った」高校生達で、世界に新たな価値をもたらす研究をし、最優秀チームに贈られるGrand-Prizeを目指しています。
4月に約1か月間クラウドファンディングを行い、誠に嬉しいことに約80万円のご支援を頂くことができました。関係者の皆様、本当にご支援ありがとうございます。
これらは約90万円の大会登録費に使用させていただきます。
しかし、現在登録費約10万円、研究費・活動費が約18万円程度が不足しており、今回追加のクラウドファンディングでのご支援を募らせていただくことになりました。内訳の詳細は、本文の下の方にあります「今回私たちがクラウドファンディングをやる目的」を御覧ください。(2024年7月19日レート)

こちらのプロジェクトページでは、合成生物学やiGEMの大会に関する説明、チームの説明はもちろんのこと、iGEM Grand Tokyoが発足して約5か月の間、どのような活動をしてきたのかなども含めて紹介をさせて頂きます。クラウドファンディングを通じてご支援していただくだけでなく、私たちの活動についても知っていただけたら嬉しいです。
また、もし目標金額を超える多くのご支援を頂いた場合、今は一部負担としてのみ計算している研究費(主に交通費)の更なる補助にまわさせていただきます。もし最終的に私たちが必要とする経費以上の金額をいただけた場合は来年度のiGEMの高校生チームへ寄付をさせて頂きます。
研究活動やパリでのiGEMへの参加にあたり、ご支援いただけますと幸いです。よろしくお願いします!
合成生物学とは
合成生物学とは細胞内で働くタンパク質やDNAをロボットの部品のように捉え、微生物の遺伝子を組み替えることで様々な機能を持つ細胞を人工的に作り出す研究分野です。微生物を特定の物質に反応させるようにしたり、物質を産出させることにより、現在人々が直面している様々な社会問題への新たな解決策を模索していくことができます。例えば、糖尿病治療に用いられる「インスリン」など、多くのタンパク質医薬品の製造を可能にしています。
iGEMとは

iGEM (the internationally Genetically Engineered Machine competition)は合成生物学の世界大会です。参加チームは自由に解決したいテーマを選び、その研究及び社会的インパクトを検証する活動に取り組みます。大会では高校生・大学生・大学院生を含めた3つの部門があり、毎年 11 月に行われるコンテストにて約6000 人の参加者とともに成果を発表します。
昨年は我々と同じ日本の高校生連合チームが参加し、総合優勝、並びに三つの特別賞を受賞し様々なメディアで取り上げられるなど、大きな反響を呼びました!そのうちの複数人をアドバイザーとして加えた新体制チームiGEM Grand Tokyoは、昨年の快挙を越え、より一層世界を動かしていくような成果を生み出していくことを目指しています。
▽▽▽iGEM公式ページ▽▽▽
https://igem.org/
iGEM Grand Tokyoとは?

東京を中心に全国から集まったiGEM 2024へ出場するチームです。SNSを通じて集まった、個性あふれる高校1〜3年生17人と昨年の最優秀賞を獲得したJapan-Unitedなどからのアドバイザー5人で構成されています。ほとんどのメンバーが
・東京大学や千葉大学、国立情報学研究所などで研究を行う「GSCプログラム」
・New York Science Academyでの研究等、国際的なプロジェクト
・Stanford大学主催の起業プログラム
で活躍しており、それぞれが専門とする得意分野を極めた高校生たちが集まっています。互いの強みは違えど、全員が「世界一」を獲得するという共通の目標を持ち、それぞれの個性を活かしながら活動しています。
私達の目標

メンバーそれぞれの専門・得意分野は違えど、私たち全員の目標はここにあります!
それぞれの個性を活かしつつ合成生物学に対する理解を養うことで、将来科学の前線に立ち、世界を創っていくような人材へ成長することを志します。
納豆を研究テーマに世界に新たな価値をもたらす研究をおこない、私たちの目標はIGEMのチームの中で最も栄誉のある賞「グランドプライズ」を獲得することです。
研究テーマ

現在は全国から集まったメンバーとともに「界面活性剤が自然環境・人体に及ぼす悪影響をなくす」という目的のもと、遺伝子組み換え技術を用いて納豆菌におけるサーファクチンの高生産を目指しています。サーファクチンとは納豆菌・枯草菌に元々微量含まれている界面活性剤であり、他の界面活性剤の100分の1の量で同等以上の効果を発揮できることで知られています。また、他の菌でもない納豆菌に着目することで、実際に遺伝子組換え納豆菌が洗剤に応用されたときに消費者に受けいれられやすいこと、納豆菌の生産するポリグルタミン酸による水質効果作用の相乗効果が期待されることなど多くの利点があげられます。
私たちは遺伝子組換え納豆を無核化し、実際に洗剤に入れるプロトタイプの開発まで行いたいと考えています。
私たち日本の高校生だからこそできる唯一無二の研究を目指し、立教大学理学部生命学科の末次正幸研究室をお借りして研究を行っていきます。
また、今回実験は立教大学理学部末次研究室にて行います。末次先生は「生命とかなにか」というテーマのもと研究に取り組まれており、昨年度の高校生優勝チーム「Japan-United」の実験を監督した先生です。モデルナが買収した企業「オリシロジェノミクス」の創業者としても幅広くご活躍されています。末次先生のご紹介、コメントは以下の通りです。

これまでの活動について
・Human Practiceの活動
Human Practice(社会との関わり)という分野の活動では自分たちのプロジェクトに対して専門家・第三者からフィードバックを得ることを目的とした活動を行っています。
iGEMでは研究が社会実装により繋がりやすくなるように、積極的に外部の機関と連携してプロジェクトを改善することを求められています。そのため、現在は椙山女学園大学の門屋亨介先生や東京農業大学の朝井計先生、千葉科学大学の柳澤泰任先生、株式会社Fermecutesの大橋由明先生など、幅広い分野の教授とオンライン通話をさせていただいております。 今後も、続けてこれらミーティングを行いプロジェクトの改善を行うと共に、プロジェクトがどのように社会に影響を及ぼすかを多角的に検討していきたいです。
椙山女学園大学 生活科学部管理栄養学科 門屋亨介先生との通話
千葉科学大学 薬学部薬学科講師 柳澤泰任先生との通話
株式会社Fermecutes 代表取締役 大橋由明先生
・実験教室の実施

iGEMにはEducationという部門の審査があり、私たち参加者以外にも生物研究の魅力を広めるために様々な教育活動を行っています。
その一環として、6月2日に株式会社リバネス様、立教大学末次研究室様のご協力の元、実験教室を行いました。
合成生物学の基本的な講義を始めとし、ブロッコリーやプロジェクトでも利用する納豆のDNA観察の実験を行い、当日参加した中学1年生~高校1年生の生徒と和気あいあいとした雰囲気で開催することができました!
財務状況
1回目のクラウドファンディング(4月実施)にて、手数料を除く約65万円の資金を募らせていただきました。
また、企業様(3社)及び個人(3名)から金銭的なご支援を頂いております。本当にメンバー一同感謝しきれません。誠にありがとうございます。
上記以外にも、物品や場所、ソフトウェアの提供などと言った形でもご支援を頂いております。重ねて御礼申し上げます。
ご協賛・ご協力いただいている企業様は以下の通りです。(6月30日時点・敬称略・50音順)
エッグフォワード株式会社
株式会社キタイエ
株式会社ナチュラルリード
株式会社フーユーミート
株式会社リバネス
SnapGene
富士フイルムビジネスイノベーション株式会社
ここで、
今回私たちがクラウドファンディングを行う目的
をご説明させていただきます。(以下、7月19日レート換算)

必要な経費は大きく分けて「大会登録費」「教育活動費」「研究費」があげられます。
1. まず、現在は約93万円の大会登録費のうち、10万円分が不足しております。
2. 加えて、iGEMの評価軸となる教育活動の費用 7万3800円が主に2つの費用により必要となります:実験教室と出張授業費です。
(i) 以前開催した実験教室に関しては、
♢プライマー(試薬)発注費=2,200円
♢ペーパーフィルター・ブロッコリー・納豆等材料費、配布資料の印刷費等=2,300円
つまり一回の実験教室で計4,500円の経費が必要となりました。このような実験居室を再度8月上旬に開催することをリバネス様と共同主催企画中であるため、前回と合算して約2回分=9,000円が必要となります。
(ii)また、ご縁があり静岡大学でもコラボ企画(「トップガン講座」)を開催させていただくこととなりました 東京駅からの往復交通費16220円×4人分=64,800
3. 最後に、立教大学末次研究室(池袋)へ毎日実験のために通うメンバーの交通費を可能な限り補助したいと考えています。
一回の補助額500円×(平均)3名分×70日間=計10万5000円 (メンバーは入れ替わりで増減しながら通うため、平均で3名分の計算。メンバーにより必要な交通費はさらに増加します。) (参考:昨年度チームは立教大学末次研へ78日間通いました。)
よって、現在は合計278,800円が必要経費として不足しております。
苦渋の決断ではありましたが、大変心苦しながらも活動に取り組むために、この度プロジェクトをさせていただくことにしました。そのため、Campfireのマージン17%を含ませていただいた、326,196≒33万円を、募らせていただきます。
また、本クラウドファンディングでご支援を頂いた分に関しては、チーム登録費の不足分、教育活動費、研究費へ充てさせていただきます。
活動のスケジュール
7月22日 第2回クラウドファンディング 募集開始
(8月31日 第2回クラウドファンディング 募集終了)
7月~9月 本実験
研究指導官にもなって頂いている立教大学の末次正幸教授のご協力により研究室をお借りし、プロジェクトの実験を進めます。その他にも「dry実験」とも呼ばれるモデルの構築や、ソフトウェアの開発を行います。
9~10月:追加実験、ウェブサイトの作成
全ての活動を記録し大会審査に出すためのサイトを制作します。他にもプレゼンテーション練習などを行い
10月21日 羽田を出発、パリ着
10月23日~26日 Jamboree(本大会)へ参加。研究などの活動についてプレゼンテーションを行う。
10月27日 パリを出発、羽田着
※Jamboreeとは、各チームが行ってきたプロジェクトをプレゼンする場であり、ここでチームが審査されます。
2024年度はパリで開催予定です。
11月下旬 リターン品の準備及び発送など
リターンについて
もしご支援をいただけます場合には、感謝の気持ちを込めたリターンを何点かご用意させて頂きました。
・ステッカー

富士フィルム株式会社様のお力のもと、我々のチームロゴを入れたステッカーのリターンをご用意させていただきます。チームロゴは、デザインが大好きなメンバーが熟考して作成したものです。東京タワーと桜がモチーフにされております。
・大会報告動画
2-10月の高校生が全力で青春をかけて挑んだ大会の軌跡をまとめた報告動画(約20分、途中経過・決勝大会の2回)をお贈りします。チームが行った活動やパリ大会での裏話など、メンバーの視点からでしか見られない映像を是非ご覧ください!
・メンバーによる感謝の通話
大会期間後(または期間中)、その結果報告と感謝をお伝えする場として30分程度お話させていただきます。パリに行った高校生が感じたことや成長したことについて、自由にご報告させていただきます。

・Tシャツへのお名前の記載

もしよければ、パリ大会活動期間中にメンバーが着用する衣類にお名前を記載いたします。(イメージ画像のお名前の欄)

チームメンバーのご紹介
私達のチームのメンバーを一部ご紹介いたします。


他にも個性あふれる、得意分野を極めたメンバーがiGEM Grand Tokyoには揃っています!他のメンバーの紹介及び詳しい自己紹介等は以下のHPをご覧ください。
▽▽▽iGEM Grand Tokyo 限定公開ホームページ▽▽▽
https://grand-tokyo.notion.site/7c8d9ece985a4511ab10506495d9da9e?v=18416d275702432385e079619e3d0d2e
プロジェクト応援者さまからのメッセージ



※応援コメントを頂いてから、研究テーマの変動があるため、内容が異なっている部分があります。ご了承ください。
Grand Tokyoのリーダーから皆様へ

<募集方式について>
本プロジェクトはAll-in方式で実施します。目標金額に満たない場合も、計画を実行し、リターンをお届けします。
本プロジェクトは法定代理人の同意のもとプロジェクトを実施します。




コメント
もっと見る